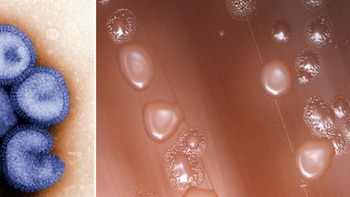
El orden de infección determina la respuesta inmunitaria frente a bacterias o virus, según una investigación

El orden de infección determina la respuesta inmunitaria frente a bacterias o virus, según una investigación
El último estudio dirigido desde la Universidad CEU San Pablo muestra que la secuencia temporal de infecciones por virus y bacterias cambia de manera significativa la respuesta de los macrófagos, lo que incide directamente en la gravedad de las complicaciones respiratorias
Sanidad advierte de un repunte de un 8,3% tuberculosis en España, aunque sigue por debajo de los niveles de 2015
Los diagnósticos de esta infección respiratoria muestran una subida este último año, con predominio en varones y personas nacidas fuera del país, mientras expertos destacan la dificultad en la detección y los nuevos desafíos epidemiológicos

Investigadores del ISCIII desarrollan organoides derivados de pacientes de glioma para investigar tratamientos
Científicos del Instituto de Salud Carlos III han creado modelos tumorales avanzados que imitan fielmente el glioma en laboratorio, lo que, según sus autores, podría acelerar el desarrollo de terapias individualizadas y mejorar la eficacia de los tratamientos futuros

El Hospital Sant Joan de Déu llama a una "financiación estable" de su red para el abordaje de patologías raras en niños
La continuidad de programas como 'Únicas' y 'ExplorER', según expertos, resulta vital para garantizar la equidad en la atención de menores con enfermedades poco frecuentes, impulsar la investigación y mejorar el acceso a terapias innovadoras y diagnóstico temprano

ISCIII constata la presencia en aire de Madrid de un hongo resistente a antifúngicos que no comporta riesgo a la salud
Un reciente análisis científico llevado a cabo por equipos del ISCIII y centros asociados ha detectado en el entorno de la capital española una variedad de aspergillus fumigatus que evidencia una creciente resistencia a tratamientos convencionales utilizados en infecciones fúngicas

El ISCIII impulsó casi 300 proyectos innovadores en salud y 100 patentes activas en 2025
El Instituto de Salud Carlos III anunció que en el último año respaldó casi 300 investigaciones disruptivas y registró al menos 97 desarrollos protegidos, reforzando su liderazgo científico y su impacto transformador en la investigación biomédica nacional

CSIF celebra que Sanidad defienda una ley de ratios de enfermeras adaptada a la complejidad asistencial
El sindicato destaca el respaldo institucional a un sistema flexible en el reparto de personal sanitario, que ahora deberá reflejarse en normativa vinculante, subraya el déficit de plantilla en España y exige aplicar medidas concretas para garantizar la seguridad

La exposición crónica a arsénico se asocia a mayor riesgo de cáncer de próstata avanzado, según un estudio
Un análisis del Instituto de Salud Carlos III revela que quienes presentan niveles altos de arsénico en las uñas tienen hasta el doble de riesgo de padecer formas agresivas de la enfermedad, subrayando la importancia de fortalecer el control ambiental

García defiende que las enmiendas a la ley de ratios de enfermeras adaptan las plantillas a la complejidad asistencial
Mónica García apuesta por revisar los criterios de asignación de profesionales de enfermería para impulsar una planificación vinculada a la demanda asistencial, destacando que una dotación adecuada permite disminuir ingresos, complicaciones y mortalidad según la evidencia científica

Expertos muestran que los telómeros revelan diferencias por género en las secuelas respiratorias tras Covid-19 grave
Investigadores españoles identifican que el envejecimiento celular tras cuadros graves de coronavirus impacta de forma distinta a mujeres y hombres en la recuperación respiratoria, lo que podría permitir mejorar estrategias médicas personalizadas en pacientes recuperados

Últimas Noticias
Debate presidencial Perú 2026 EN VIVO HOY: tercera fecha con 12 postulantes, temas clave y el minuto a minuto del encuentro del 25 de marzo
Hoy es la tercera y última fecha de la primera fase del debate presidencial rumbo a las elecciones del 12 de abril. Se espera que sea un debate de ideas y propuestas, y menos puyazos

Alimentación para el Bienestar Edomex 2026: estas son las fechas, documentos y requisitos para registrarse
Las autoridades del Estado de México iniciaron el proceso para que ciudadanas en situación de vulnerabilidad puedan ser acreedoras del apoyo

Así está la confianza de las empresas en medio de la incertidumbre social, política y económica de Colombia
Fedesarrollo identificó señales opuestas al inicio del año: la industria empezó a recuperarse mientras la construcción enfrentó un ciclo adverso y el comercio experimentó mayor cautela
Manifestaciones, accidentes, bloqueos en CDMX y Edomex hoy 25 de marzo: manifestantes impiden el paso en Tlalpan
Mantente informado en tiempo real sobre el acontecer del Valle de México

Alcalde de Cajamarca, su gerente y su secretaria son arrestados por acusación de solicitar coima de S/200 mil a un empresario
El alcalde de Miguel Iglesias y dos altos funcionarios municipales fueron detenidos tras un operativo anticorrupción. Las autoridades los acusan de exigir soborno a un empresario a cambio de favores administrativos en una obra local

